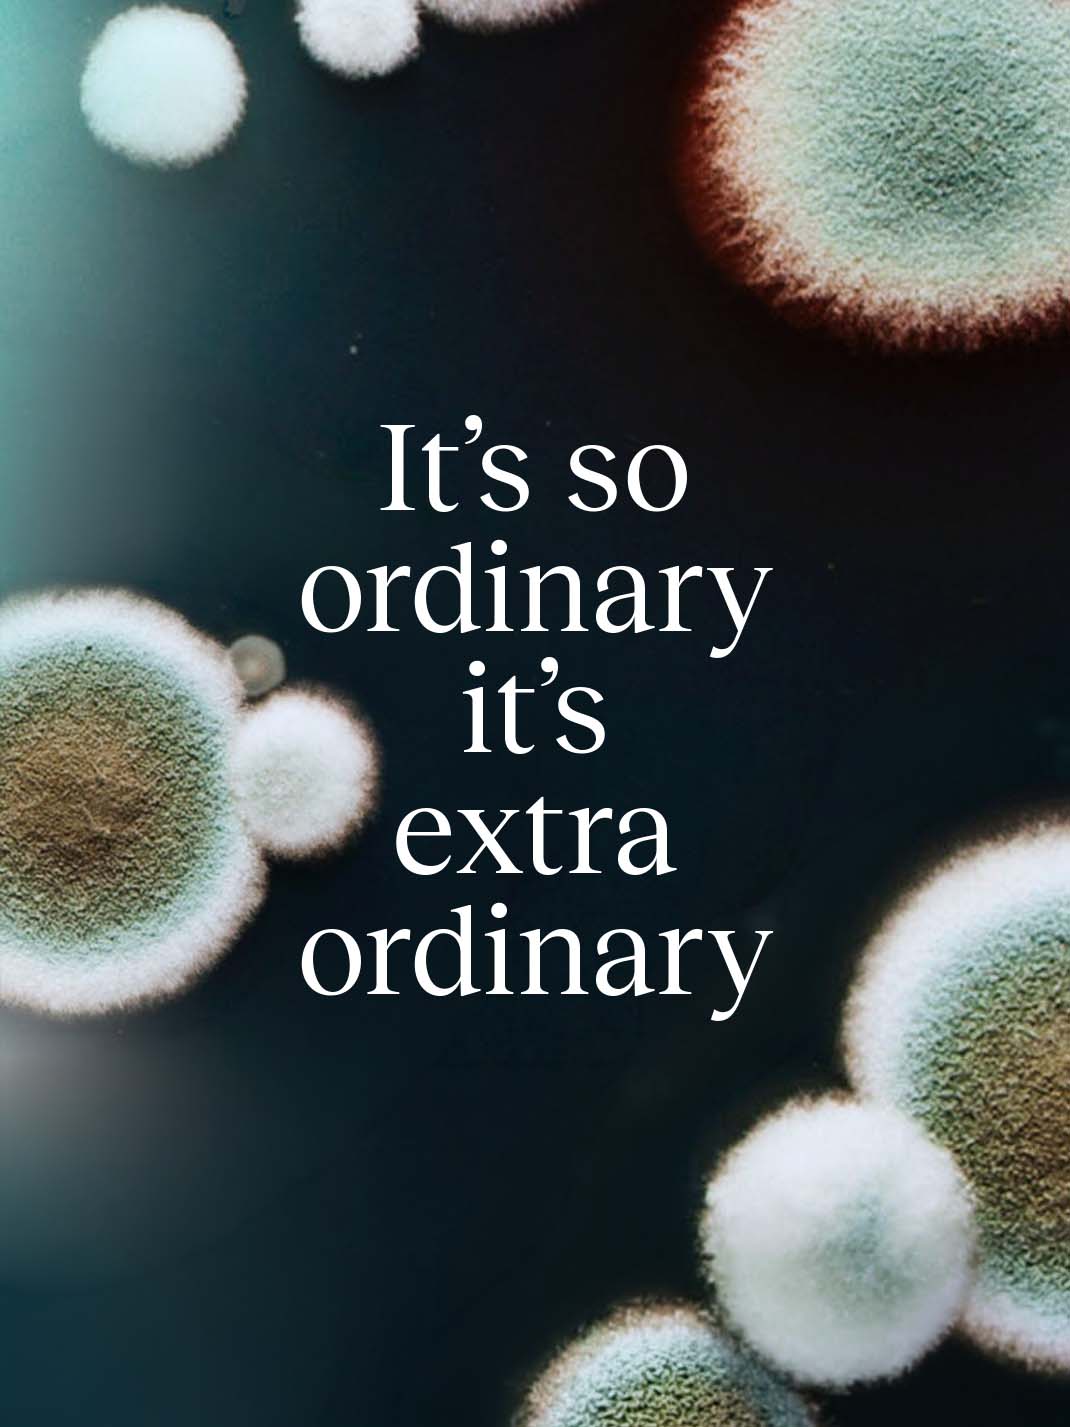

Abolis
2023


INSIGHT
INSIGHT
Tomorrow is still made of yesterday
Our society’s reliance on oil is no longer sustainable.
Total dependence on a non-renewable resource, non-recyclable products, and escalating pollution are pushing our world toward unlivable conditions.
Tomorrow is still made of yesterday
Our society’s reliance on oil is no longer sustainable.
Total dependence on a non-renewable resource, non-recyclable products, and escalating pollution are pushing our world toward unlivable conditions.
IDEA
IDEA
What Life Can Do
What nature doesn’t create, nature cannot undo.
But what nature creates, nature can regenerate.
The future of life lies within life itself.
It’s time to return to a biology-based chemistry.
What Life Can Do
What nature doesn’t create, nature cannot undo.
But what nature creates, nature can regenerate.
The future of life lies within life itself.
It’s time to return to a biology-based chemistry.

STUDIO
Cenitz Studio
Credits
Julien Tardif
Creative Director
Studio
Cenitz Studio
Credits
Julien Tardif
Creative Director


